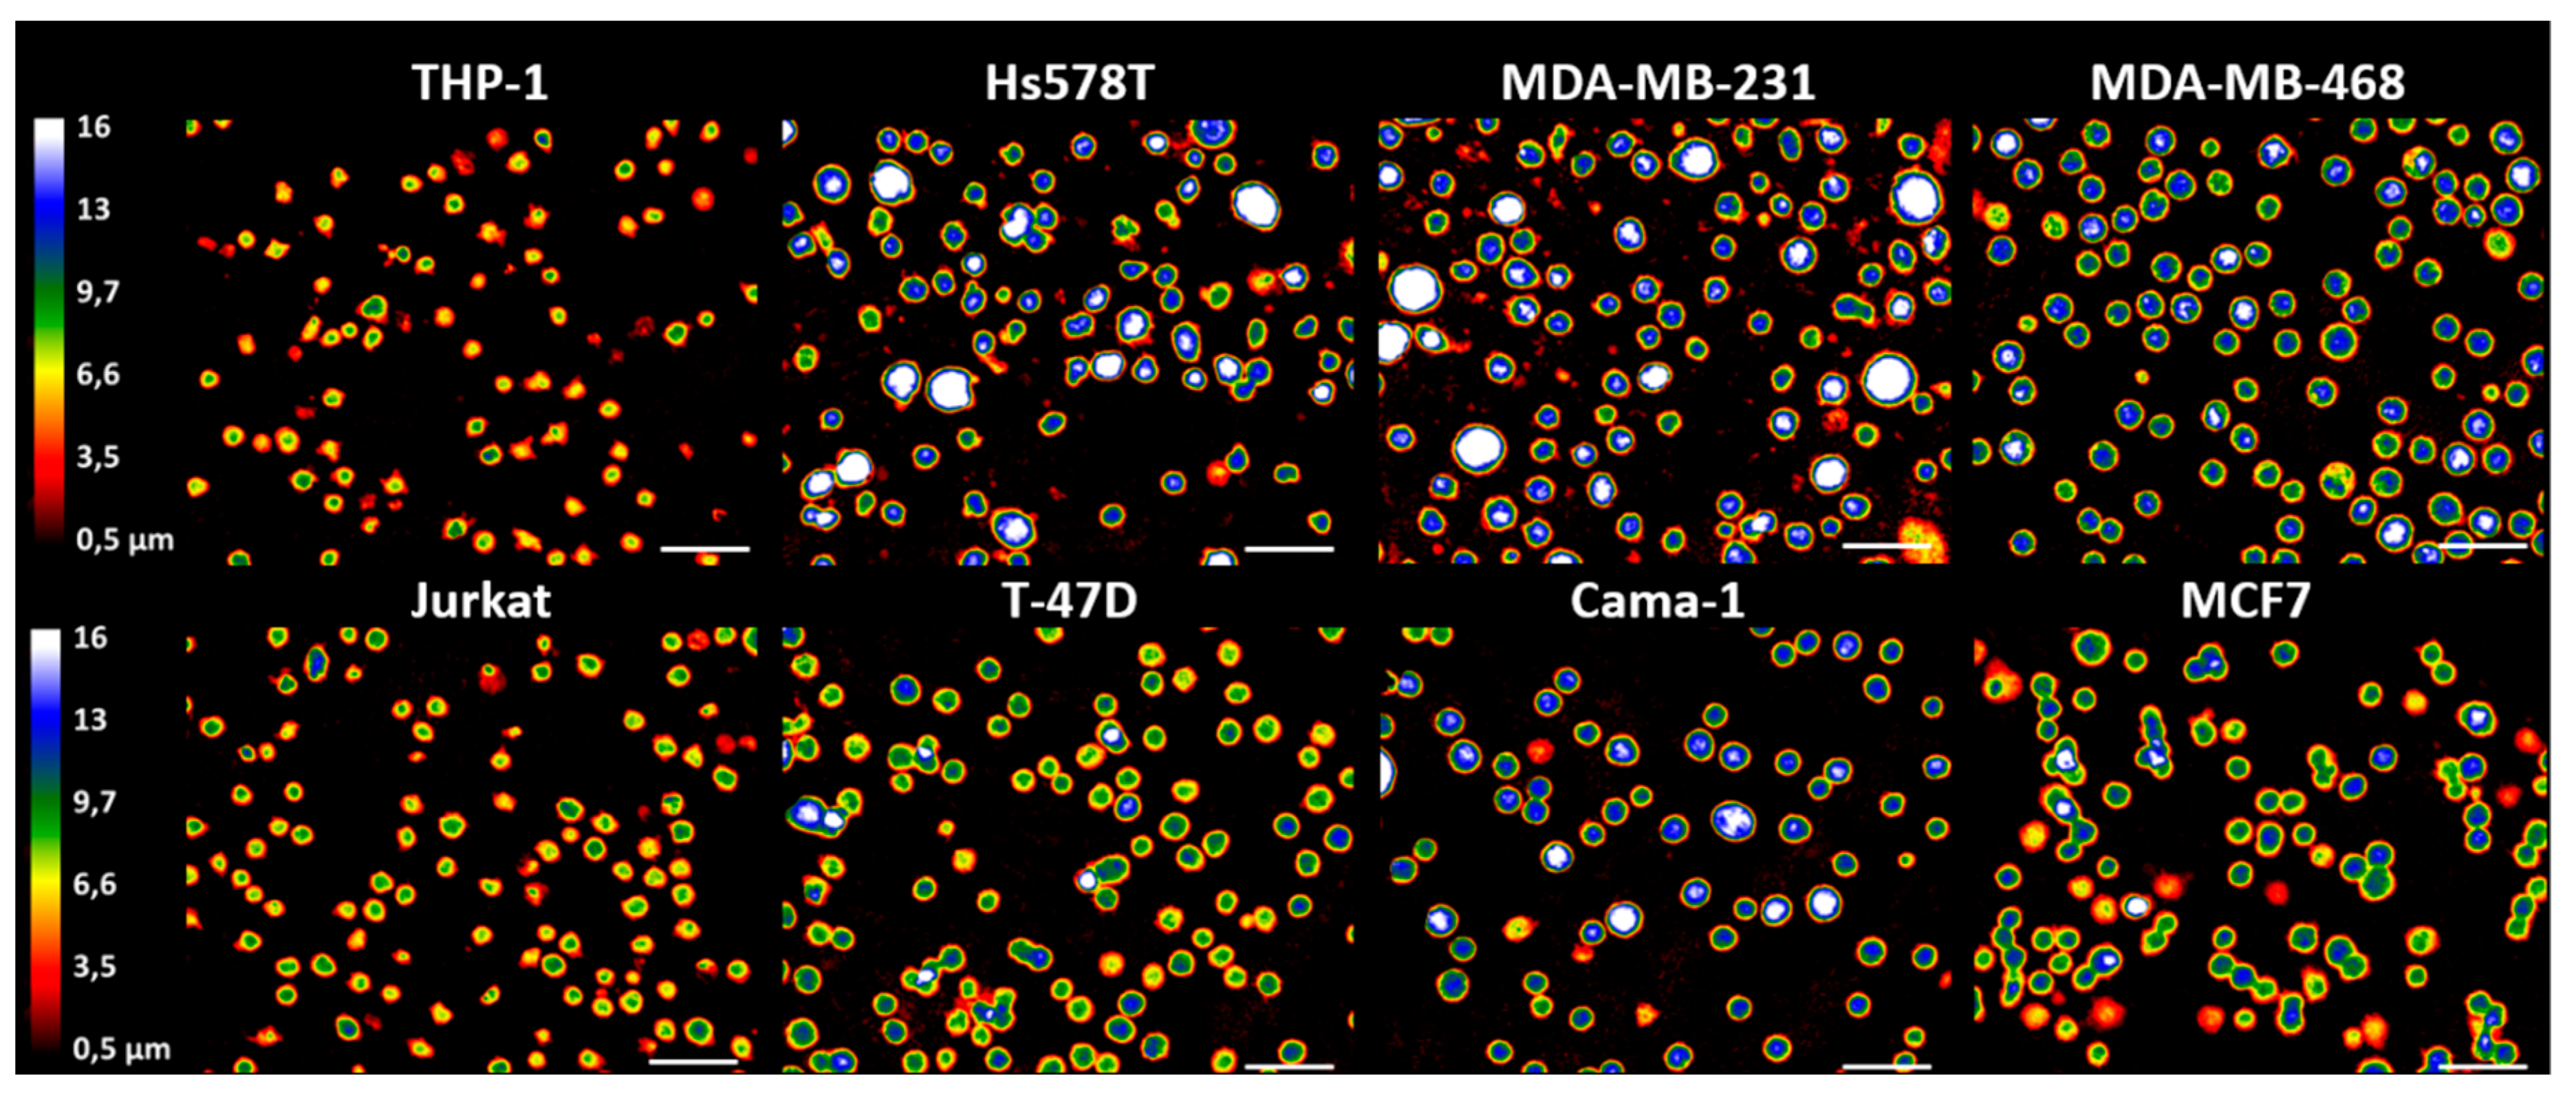
Applsci 10 04854 g002 Applsci 10 04854 g002

Discrimination between Breast Cancer Cells and White Blood Cells by Non-Invasive Measurements: Implications for a Novel In Vitro-Based Circulating Tumor Cell Model Using Digital Holographic Cytometry
Abstract
1. Introduction
2. Materials and Methods
2.1. Cell Culture
2.2. Flow Cytometry Analysis
2.3. DHC and Computer Software
2.4. Statistical Analysis
3. Results
3.1. There Is Low or No Expression of EpCAM in Triple Negative Breast Cancer Cell Lines
3.2. WBC Lines and Breast Cancer Cell Lines Presented in 2D Holograms with DHC
3.3. The Morphology Parameters Analyzed with DHC Clearly Discriminate between Breast Cancer Cells and WBC Lines
4. Discussion
5. Conclusions
Author Contributions
Funding
Acknowledgments
Conflicts of Interest
References
- Youlden, D.R.; Cramb, S.; Dunn, N.A.M.; Muller, J.M.; Pyke, C.; Baade, P. The descriptive epidemiology of female breast cancer: An international comparison of screening, incidence, survival and mortality. Cancer Epidemiol. 2012, 36, 237–248. [Google Scholar] [CrossRef]
- Weigelt, B.; Peterse, J.L.; Veer, L.J.V. Breast cancer metastasis: Markers and models. Nat. Rev. Cancer 2005, 5, 591–602. [Google Scholar] [CrossRef] [PubMed]
- Cardiff, R.D.; Borowsky, A.D. At last: Classification of human mammary cells elucidates breast cancer origins. J. Clin. Investig. 2014, 124, 478–480. [Google Scholar] [CrossRef] [PubMed][Green Version]
- Giulianelli, S.; Molinolo, A.; Lanari, C. Targeting Progesterone Receptors in Breast Cancer. Nitric Oxide 2013, 93, 161–184. [Google Scholar] [CrossRef]
- Reis-Filho, J.S.; Tutt, A.N.J. Triple negative tumours: A critical review. Histopathology 2007, 52, 108–118. [Google Scholar] [CrossRef] [PubMed]
- Gu, G.; Dustin, D.; Fuqua, S.A. Targeted therapy for breast cancer and molecular mechanisms of resistance to treatment. Curr. Opin. Pharmacol. 2016, 31, 97–103. [Google Scholar] [CrossRef]
- Yang, F.; Wang, Y.; Li, Q.; Cao, L.; Sun, Z.; Jin, J.; Fang, H.; Zhu, A.; Li, Y.; Zhang, W.; et al. Intratumor heterogeneity predicts metastasis of triple-negative breast cancer. Carcinogenesis 2017, 38, 900–909. [Google Scholar] [CrossRef] [PubMed]
- Puisieux, A.; Pommier, R.M.; Morel, A.P.; Lavial, F. Cellular pliancy and the multistep process of tumorigenesis. Cancer Cell 2018, 33, 164–172. [Google Scholar] [CrossRef]
- Pastushenko, I.; Blanpain, C. EMT Transition states during tumor progression and metastasis. Trends Cell Biol. 2019, 29, 212–226. [Google Scholar] [CrossRef]
- Cristofanilli, M.; Budd, G.T.; Ellis, M.J.; Stopeck, A.; Matera, J.; Miller, M.C.; Reuben, J.M.; Doyle, G.V.; Allard, W.J.; Terstappen, L.W.; et al. Circulating tumor cells, disease progression, and survival in metastatic breast cancer. N. Engl. J. Med. 2004, 351, 781–791. [Google Scholar] [CrossRef]
- Imrich, S.; Hachmeister, M.; Gires, O. EpCAM and its potential role in tumor-initiating cells. Cell Adhes. Migr. 2012, 6, 30–38. [Google Scholar] [CrossRef] [PubMed]
- Marhaba, R.; Klingbeil, P.; Nuebel, T.; Nazarenko, I.; Buechler, M.W.; Zoeller, M. CD44 and EpCAM: Cancer-initiating cell markers. Curr. Mol. Med. 2008, 8, 784–804. [Google Scholar] [CrossRef] [PubMed]
- Coumans, F.; Doggen, C.J.M.; Attard, G.; De Bono, J.; Terstappen, L.W.M.M. All circulating EpCAM+ CK+ CD45− objects predict overall survival in castration-resistant prostate cancer. Ann. Oncol. 2010, 21, 1851–1857. [Google Scholar] [CrossRef]
- Fehm, T.; Solomayer, E.; Meng, S.; Tucker, T.; Lane, N.; Wang, J.; Gebauer, G. Methods for isolating circulating epithelial cells and criteria for their classification as carcinoma cells. Cytotherapy 2005, 7, 171–185. [Google Scholar] [CrossRef]
- Rosenberg, R.; Gertler, R.; Friederichs, J.; Fuehrer, K.; Dahm, M.; Phelps, R.; Thorban, S.; Nekarda, H.; Siewert, J.R. Comparison of two density gradient centrifugation systems for the enrichment of disseminated tumor cells in blood. Cytometry 2002, 49, 150–158. [Google Scholar] [CrossRef] [PubMed]
- Vona, G.; Sabile, A.; Louha, M.; Sitruk, V.; Romana, S.P.; Schütze, K.; Capron, F.; Franco, D.; Pazzagli, M.; Vekemans, M.; et al. Isolation by size of epithelial tumor cells. Am. J. Pathol. 2000, 156, 57–63. [Google Scholar] [CrossRef]
- Coumans, F.A.W.; Van Dalum, G.; Beck, M.; Terstappen, L.W.M.M. Filter Characteristics influencing circulating tumor cell enrichment from whole blood. PLoS ONE 2013, 8, e61770. [Google Scholar] [CrossRef]
- Zheng, S.Y.; Lin, H.K.; Lu, B.; Williams, A.; Datar, R.; Cote, R.J.; Tai, Y.C. 3D microfilter device for viable circulating tumor cell (CTC) enrichment from blood. Biomed. Microdevices 2011, 13, 203–213. [Google Scholar] [CrossRef]
- Jin, C.; Mcfaul, S.M.; Duffy, S.P.; Deng, X.; Tavassoli, P.; Black, P.C.; Ma, H. Technologies for label-free separation of circulating tumor cells: From historical foundations to recent developments. Lab Chip 2014, 14, 32–44. [Google Scholar] [CrossRef]
- Yu, X.; Hong, J.; Liu, C.; Cross, M.; Haynie, D.T.; Kim, M.K. Four-dimensional motility tracking of biological cells by digital holographic microscopy. J. Biomed. Opt. 2014, 19, 045001. [Google Scholar] [CrossRef]
- Marquet, P.; Depeursinge, C.; Magistretti, P.J. Review of quantitative phase-digital holographic microscopy: Promising novel imaging technique to resolve neuronal network activity and identify cellular biomarkers of psychiatric disorders. Neurophotonics 2014, 1, 020901. [Google Scholar] [CrossRef] [PubMed]
- Kemper, B.; Wibbeling, J.; Kastl, L.; Schnekenburger, J.; Ketelhut, S. Multimodal label-free growth and morphology characterization of different cell types in a single culture with quantitative digital holographic phase microscopy. In Proceedings of the 1st Conference on Quantitative Phase Imaging (QPI), San Francisco, CA, USA, 7–10 February 2014. [Google Scholar]
- Alm, K.; El-Schich, Z.; Falck, M.; Wingren, A.G.; Janicke, B.; Oredsso, S. Cells and Holograms-Holograms and Digital Holographic Microscopy as a Tool to Study the Morphology of Living Cells. In Holography-Basic Principles and Contemporary Applications; Mihaylova, E., Ed.; IntechOpen: London, UK, 2013. [Google Scholar]
- Majeed, H.; Sridharan, S.; Mir, M.; Ma, L.; Min, E.; Jung, W.; Popescu, G. Quantitative phase imaging for medical diagnosis. J. Biophotonics 2016, 10, 177–205. [Google Scholar] [CrossRef]
- Wingren, A.G. Moving into a new dimension: Tracking migrating cells with digital holographic cytometry in 3D. Cytom. Part A 2018, 95, 144–146. [Google Scholar] [CrossRef]
- Zhang, Y.; Judson, R.L. Evaluation of holographic imaging cytometer holomonitor M4® motility applications. Cytom. Part A 2018, 93, 1125–1131. [Google Scholar] [CrossRef] [PubMed]
- Bettenworth, D.; Bokemeyer, A.; Poremba, C.; Ding, N.S.; Ketelhut, S.; Lenz, P.; Kemper, B. Quantitative phase microscopy for evaluation of intestinal inflammation and wound healing utilizing label-free biophysical markers. Histol. Histopathol. 2017, 33, 417–432. [Google Scholar] [PubMed]
- Anand, A.; Chhaniwal, V.K.; Patel, N.R.; Javidi, B. Automatic identification of malaria-infected RBC with digital holographic microscopy using correlation algorithms. IEEE Photonics J. 2012, 4, 1456–1464. [Google Scholar] [CrossRef]
- Benzerdjeb, N.; Garbar, C.; Camparo, P.; Sevestre, H. Digital holographic microscopy as screening tool for cervical cancer preliminary study. Cancer Cytopathol. 2016, 124, 573–580. [Google Scholar] [CrossRef]
- Keller, L.; Werner, S.; Pantel, K. Biology and clinical relevance of EpCAM. Cell Stress 2019, 3, 165–180. [Google Scholar] [CrossRef]
- Allard, W.J. Tumor cells circulate in the peripheral blood of all major carcinomas but not in healthy subjects or patients with nonmalignant diseases. Clin. Cancer Res. 2004, 10, 6897–6904. [Google Scholar] [CrossRef]
- Lecharpentier, A.; Vielh, P.; Perez-Moreno, P.; Planchard, D.; Soria, J.C.; Farace, F. Detection of circulating tumour cells with a hybrid (epithelial/mesenchymal) phenotype in patients with metastatic non-small cell lung cancer. Br. J. Cancer 2011, 105, 1338–1341. [Google Scholar] [CrossRef]
- DeSitter, I.; Guerrouahen, B.S.; Benali-Furet, N.; Wechsler, J.; Jänne, P.A.; Kuang, Y.; Yanagita, M.; Wang, L.; Berkowitz, J.A.; Distel, R.J.; et al. A new device for rapid isolation by size and characterization of rare circulating tumor cells. Anticancer. Res. 2011, 31, 427–441. [Google Scholar]
- Zabaglo, L.; Ormerod, M.G.; Parton, M.; Ring, A.E.; Smith, I.E.; Dowsett, M. Cell filtration-laser scanning cytometry for the characterisation of circulating breast cancer cells. Cytom. Part A 2003, 55, 102–108. [Google Scholar] [CrossRef] [PubMed]
- Ribeiro-Samy, S.; Oliveira, M.I.; Pereira-Veiga, T.; Muinelo-Romay, L.; Carvalho, S.; Gaspar, J.; Freitas, P.P.; López-López, R.; Costa, C.; Diéguez, L. Fast and efficient microfluidic cell filter for isolation of circulating tumor cells from unprocessed whole blood of colorectal cancer patients. Sci. Rep. 2019, 9, 1–12. [Google Scholar] [CrossRef] [PubMed]
- Hosokawa, M.; Kenmotsu, H.; Koh, Y.; Yoshino, T.; Yoshikawa, T.; Naito, T.; Takahashi, T.; Murakami, H.; Nakamura, Y.; Tsuya, A.; et al. Size-based isolation of circulating tumor cells in lung cancer patients using a microcavity array system. PLoS ONE 2013, 8, e67466. [Google Scholar] [CrossRef] [PubMed]
- Mihailescu, M.; Scarlat, M.; Gheorghiu, A.; Costescu, J.; Kusko, M.; Paun, I.A.; Scarlat, E. Automated imaging, identification, and counting of similar cells from digital hologram reconstructions. Appl. Opt. 2011, 50, 3589–3597. [Google Scholar] [CrossRef]
- Kemmler, M.; Fratz, M.; Saum, N.; Giel, D.; Brandenburg, A.; Hoffmann, C. Noninvasive time-dependent cytometry monitoring by digital holography. J. Biomed. Opt. 2007, 12, 064002. [Google Scholar] [CrossRef]
- El-Schich, Z.; Molder, A.; Tassidis, H.; Härkönen, P.; Miniotis, M.F.; Wingren, A.G. Induction of morphological changes in death-induced cancer cells monitored by holographic microscopy. J. Struct. Biol. 2015, 189, 207–212. [Google Scholar] [CrossRef]
- El-Schich, Z.; Kamlund, S.; Janicke, B.; Wingren, A.G. Holography: The Usefulness of Digital Holographic Microscopy for Clinical Diagnostics; IntechOpen: London, UK, 2017; pp. 319–333. [Google Scholar]
- El-Schich, Z.; Nilsson, E.; Gerdtsson, A.S.; Wingren, C.; Wingren, A.G. Interfacing antibody-based microarrays and digital holography enables label-free detection for loss of cell volume. Future Sci. OA 2015, 1, 1–11. [Google Scholar] [CrossRef]
- El-Schich, Z.; Mölder, A.L.; Wingren, A.G. Quantitative phase imaging for label-free analysis of cancer cells—Focus on digital holographic microscopy. Appl. Sci. 2018, 8, 1027. [Google Scholar] [CrossRef]
- Luther, E.; Mendes, L.P.; Pan, J.; Costa, D.F.; Torchilin, V.P. Applications of label-free, quantitative phase holographic imaging cytometry to the development of multi-specific nanoscale pharmaceutical formulations. Cytom. Part A 2017, 91, 412–423. [Google Scholar] [CrossRef]
- Patel, M.; Feith, M.; Janicke, B.; Alm, K.; El-Schich, Z. Evaluation of the impact of imprinted polymer particles on morphology and motility of breast cancer cells by using digital holographic cytometry. Appl. Sci. 2020, 10, 750. [Google Scholar] [CrossRef]
- Castro-Giner, F.; Aceto, N. Tracking cancer progression: From circulating tumor cells to metastasis. Genome Med. 2020, 12, 1–12. [Google Scholar] [CrossRef]
- Roitshtain, D.; Wolbromsky, L.; Bal, E.; Greenspan, H.; Satterwhite, L.L.; Shaked, N.T. Quantitative phase microscopy spatial signatures of cancer cells. Cytom. Part A 2017, 91, 482–493. [Google Scholar] [CrossRef] [PubMed]
- Hejna, M.; Jorapur, A.; Song, J.S.; Judson-Torres, R. High accuracy label-free classification of single-cell kinetic states from holographic cytometry of human melanoma cells. Sci. Rep. 2017, 7, 11943. [Google Scholar] [CrossRef]
- Singh, D.K.; Ahrens, C.; Li, W.; Vanapalli, S.A. Label-free, high-throughput holographic screening and enumeration of tumor cells in blood. Lab Chip 2017, 17, 2920–2932. [Google Scholar] [CrossRef]
- Khan, F.Z.; Hutcheson, J.; Hunter, C.J.; Powless, A.J.; Benson, D.M.; Fritsch, I.; Muldoon, T.J. Redox-magnetohydrodynamically controlled fluid flow with poly(3,4-ethylenedioxythiophene) coupled to an epitaxial light sheet confocal microscope for image cytometry applications. Anal. Chem. 2018, 90, 7862–7870. [Google Scholar] [CrossRef]

| Jurkat | THP-1 | Hs-578T | MDA-MB-231 | MDA-MB-468 | T-47D | Cama-1 | MCF7 | |
|---|---|---|---|---|---|---|---|---|
| EpCAM % | 0.2 | 0.1 | 0.1 | 0.3 | 11.7 | 48.6 | 79.9 | 91.4 |
| CD45 % | 100 | 100 | 0.1 | 0.4 | 0.1 | 1.2 | 1.2 | 0.9 |
© 2020 by the authors. Licensee MDPI, Basel, Switzerland. This article is an open access article distributed under the terms and conditions of the Creative Commons Attribution (CC BY) license (http://creativecommons.org/licenses/by/4.0/).
Share and Cite
El-Schich, Z.; Janicke, B.; Alm, K.; Dizeyi, N.; L. Persson, J.; Gjörloff Wingren, A. Discrimination between Breast Cancer Cells and White Blood Cells by Non-Invasive Measurements: Implications for a Novel In Vitro-Based Circulating Tumor Cell Model Using Digital Holographic Cytometry. Appl. Sci. 2020, 10, 4854. https://doi.org/10.3390/app10144854
El-Schich Z, Janicke B, Alm K, Dizeyi N, L. Persson J, Gjörloff Wingren A. Discrimination between Breast Cancer Cells and White Blood Cells by Non-Invasive Measurements: Implications for a Novel In Vitro-Based Circulating Tumor Cell Model Using Digital Holographic Cytometry. Applied Sciences. 2020; 10(14):4854. https://doi.org/10.3390/app10144854
Chicago/Turabian StyleEl-Schich, Zahra, Birgit Janicke, Kersti Alm, Nishtman Dizeyi, Jenny L. Persson, and Anette Gjörloff Wingren. 2020. "Discrimination between Breast Cancer Cells and White Blood Cells by Non-Invasive Measurements: Implications for a Novel In Vitro-Based Circulating Tumor Cell Model Using Digital Holographic Cytometry" Applied Sciences 10, no. 14: 4854. https://doi.org/10.3390/app10144854
APA StyleEl-Schich, Z., Janicke, B., Alm, K., Dizeyi, N., L. Persson, J., & Gjörloff Wingren, A. (2020). Discrimination between Breast Cancer Cells and White Blood Cells by Non-Invasive Measurements: Implications for a Novel In Vitro-Based Circulating Tumor Cell Model Using Digital Holographic Cytometry. Applied Sciences, 10(14), 4854. https://doi.org/10.3390/app10144854

